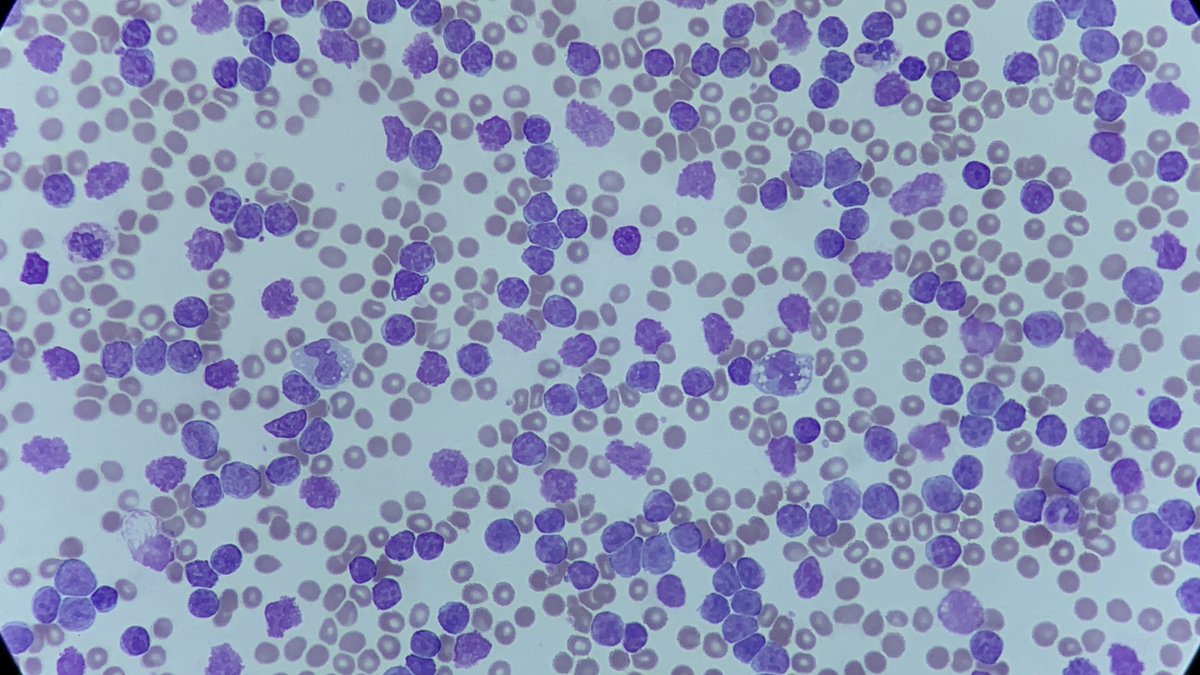
Only Cells tweet media
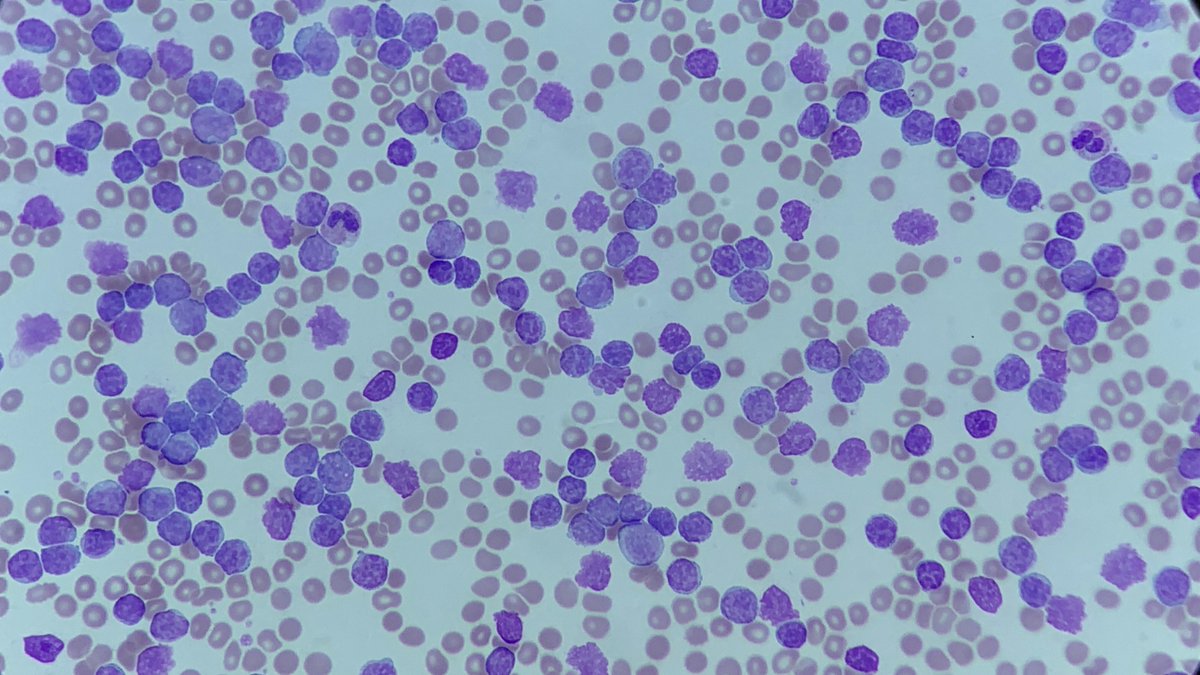
Only Cells tweet media
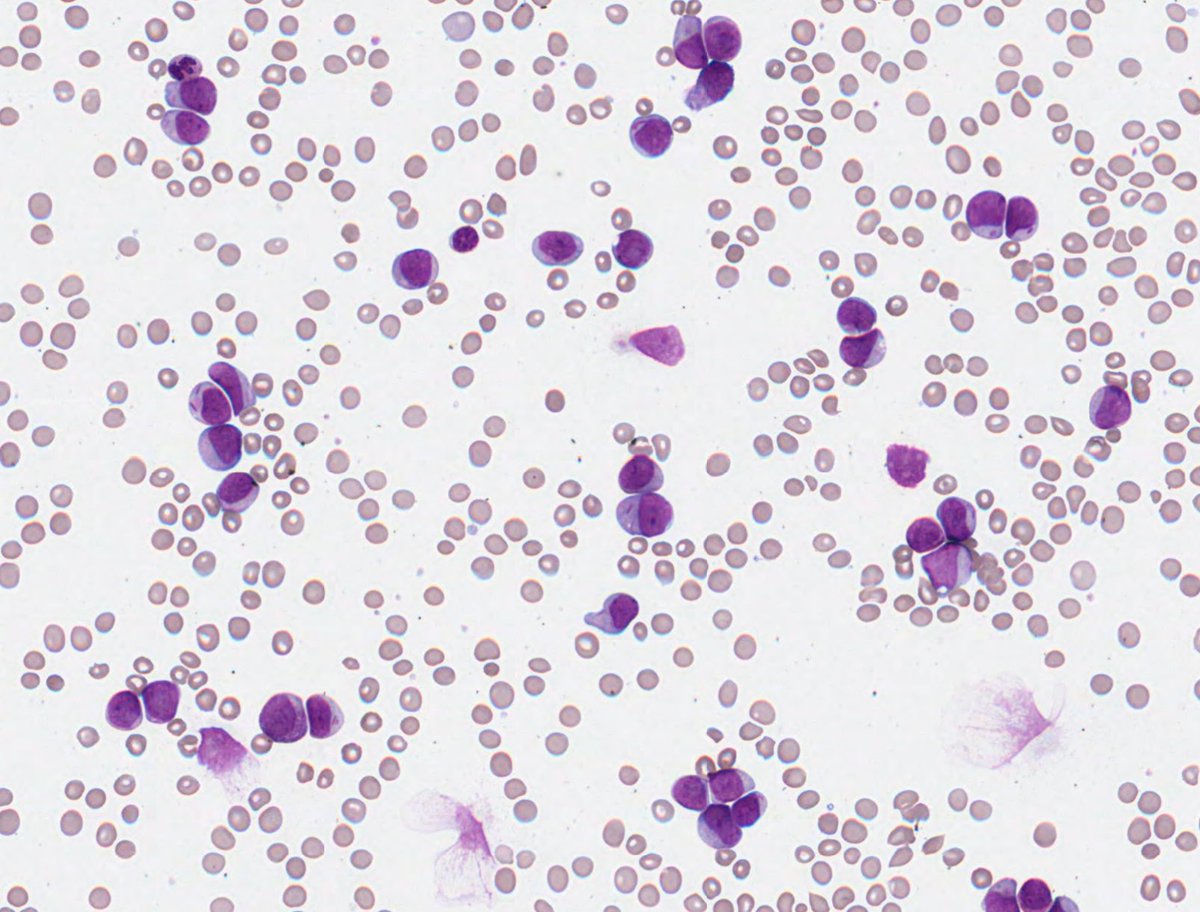
Only Cells tweet media
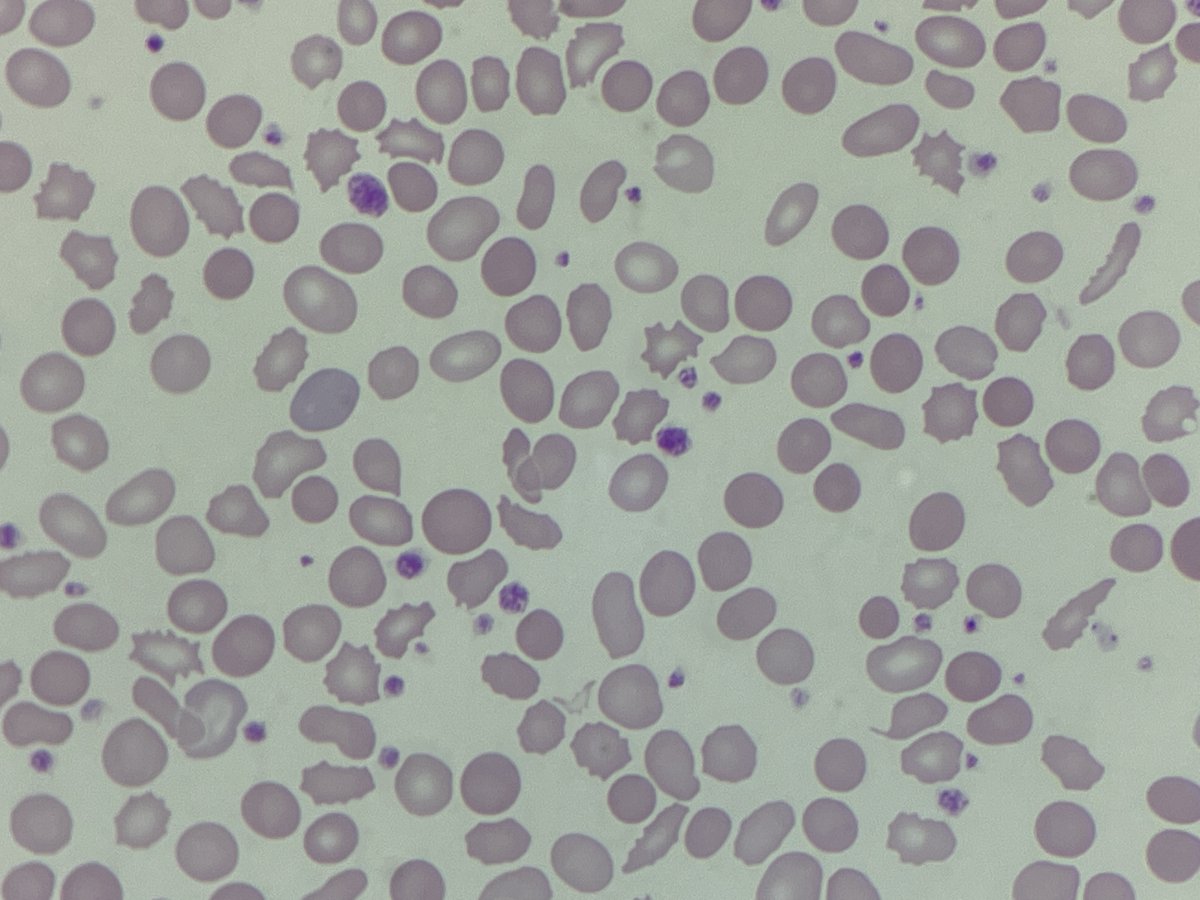
Only Cells tweet media
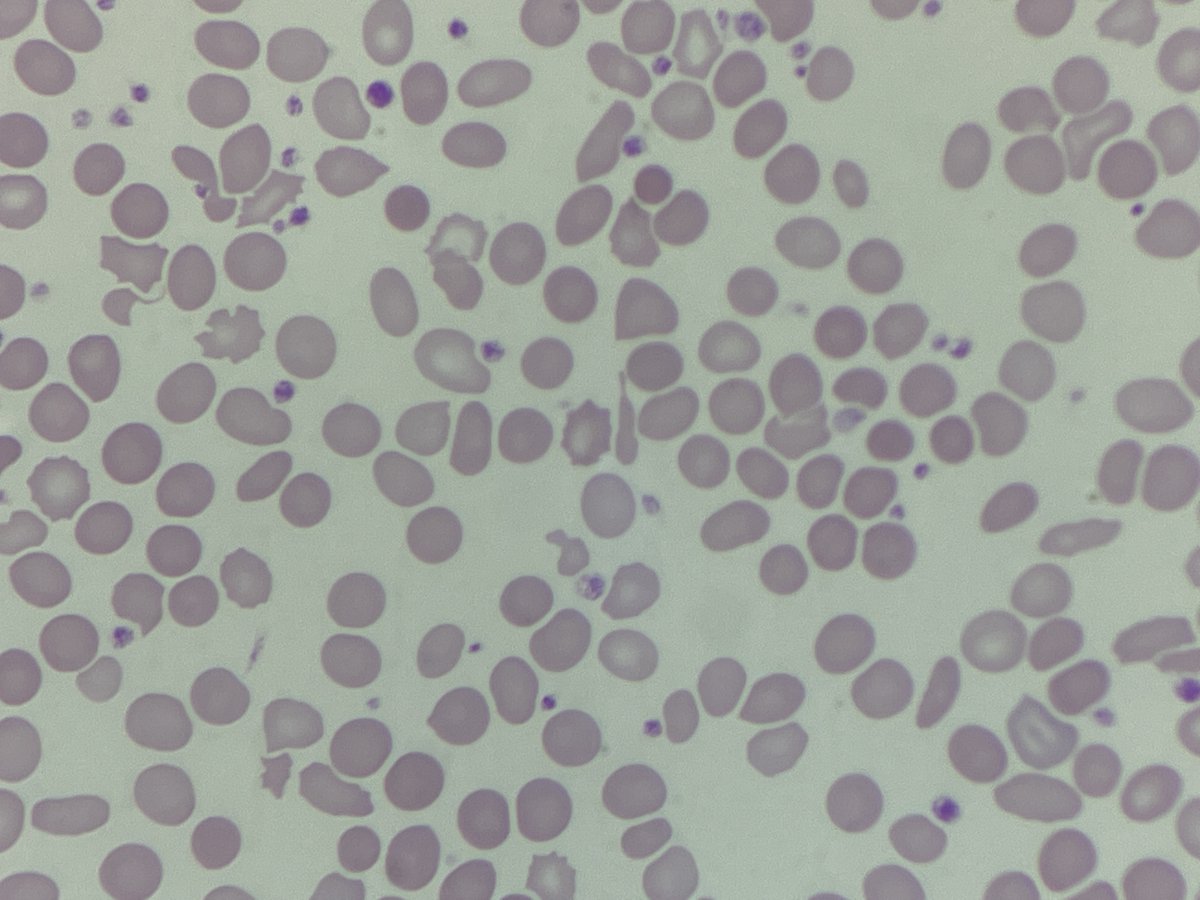
Only Cells tweet media

WeBMS
9.3K posts

@WeBMScientists
Bringing together biomedical scientists across the UK. Tag @WeBMScientists or use #WeBMS to start or join a conversation. RT for discussion - not endorsement.

🩸#MorphologyMonday | Case MM250728 onlycells.co.uk/mm250804/ This week’s case comes from a 69-year-old male with fatigue, back pain, and a history of recurrent infections. His FBC shows normocytic anaemia and mild thrombocytopaenia. Biochemistry reveals raised total protein and calcium. What’s the story behind these results? Check out the blood film and share your thoughts. #OnlyCells #BloodFilm #LabDiagnostics #Haematology

Basics Basics Basics 😀 Friday Morphology🤪 Please Identify this Cell on this Blood Film ..... #medtwitter #meded #hematology #medicine

🩸#MorphologyMonday | Case MM250818 onlycells.co.uk/mm250818/ This week's case is from a 35 year old who presented with: - Fatigue and pallor - Easy bruising - Reduced urine output - Mild abdominal pain following GI illness Their FBC result showed: - Hb: 113g/L - WBC: 5.46 ×10⁹/L - PLT: 16 ×10⁹/L A blood film was made due to markedly low platelet count. Images are attached. To see more images, and further test results, you can do so using the link at the beginning of this post. What are your thoughts? #OnlyCells #LabDiagnostics #BloodFilm #RedCells

🩸#MorphologyMonday | Case MM250901 onlycells.co.uk/mm250901/ This week's case is from a 6 year old with chronic anaemia + jaundice + splenomegaly. Some of their laboratory results showed: - Hb: 78 g/L - MCV: 55 fL - MCHC: 365 g/L - Reticulocytes: 9% - Total Bilirubin: Elevated (predominantly indirect) - LDH: Raised - Direct Antiglobulin Test (DAT): Negative Blood film images below 👇 What do you think it could be? 🧐🤔 #LabDiagnostics #RedCell #BloodFilm #OnlyCells
